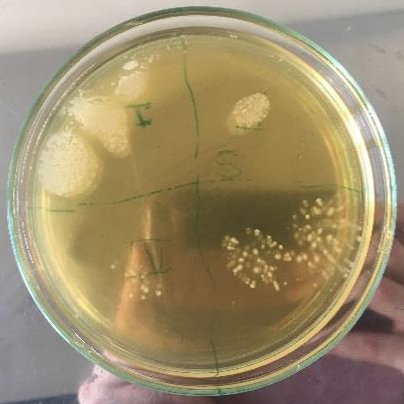

步琦實驗室設備貿易(上海)有限公司
 白金會員
白金會員 已認證
已認證

步琦實驗室設備貿易(上海)有限公司
 白金會員
白金會員 已認證
已認證

瑞士步琦
冷凍干燥含酵母菌的微球應用
冷凍干燥應用
益生菌是一種有益于人體健康的微生物,常被用于改善腸道菌群。微膠囊包埋技術可以幫助保護菌株,延長其在體內的存活時間,不易受外界環境的影響而失活。因此,在生產益生菌產品時,需要考慮選擇合適的微膠囊技術,以確保益生菌的穩定性和活性。下面這篇應用非常好的結合了微膠囊包埋和冷凍干燥技術,證明菌種經過包埋干燥后仍具有生物活性,為發酵工藝和食品轉化等領域開辟新的可能性。
1
介紹
冷凍干燥,也稱為凍干是一種非常通用的脫水方法,常用于保存微生物、食物或藥物,如蛋白質類藥物。它將冷凍和干燥結合在一個獨特的操作中,可以創造出高質量的干燥終產品。
冷凍干燥通常用于保存微生物培養物,因為它具有不可忽視的優點:儲存的方便性和增加郵寄微生物的可能性。此外,制得的產品只需要少量維護,培養基在儲存過程中不會受到污染,微生物可以長時間保持活力。
然而,眾所周知,冷凍干燥技術對微生物至關重要,因為它對微生物的生存能力和生理狀態都有負面影響。根據方法和生物體的不同,微生物存活率也各有不同;然而,活力水平明顯低于液氮儲存 2。觀察到的活力下降主要是由于一些不良副作用引起的,例如細胞內冰晶的形成1、敏感蛋白的變性或在此過程中膜脂質的物理狀態發生一些不可逆的變化 3,5。為了防止這種影響,通常在冷凍或冷凍干燥前使用脫脂牛奶、蔗糖、甘油、 DMSO 或海藻糖等作為凍干保護物質1,3。
據報道,海藻糖在干燥、冷凍、滲透脅迫和熱休克等極端環境下對酵母和細菌具有保護作用。這些保護效果與膜的穩定和酶活性的保存有關。關于海藻糖的保護作用,已經報道了幾種假設。一些報道認為它的作用是通過多個外部氫鍵取代參與維持蛋白質三級結構的水分子,另一些報道認為它形成玻璃態結構以確保物理穩定性。
除了發酵過程或食品轉化,釀酒酵母或乳酸菌等微生物在益生菌膳食食品和飼料補充劑領域具有重要的經濟意義。然而,這些應用需要在儲存過程中保持細胞活力。通過造粒和冷凍干燥技術相結合,可以得到大小和組成均勻的無塵顆粒。由于具有更高的顆粒表面積,這使得產品將具有良好的顆粒流動性,更容易掌握的劑量和更快的產品復原性。盡管存在上述挑戰,冷凍干燥仍然是一種酵母、孢子真菌和細菌的方便保存方法,因為它們的長期生存能力通常保持得相當好,而且菌株的儲存和分發要求也很簡單。
因此,本應用旨在生產釀酒酵母顆粒作為模型微生物,使用微膠囊造粒儀 Encapsulator B-390 作為造粒機,將酵母懸浮液擠壓進入液氮中形成單分散球體,然后使用冷凍干燥機 Lyovapor? L – 200 進行冷凍干燥處理。
2
儀器,試劑和器材
儀器:
ESCO NordicSafe, Biosafety Cabinet Class II
BUCHI 微膠囊造粒儀 Encapsulator B-390
BUCHI 冷凍干燥機 LyovaporTM L-200 Pro,干燥腔體搭配可加熱擱板
BUCHI LyovaporTM Software
試劑:
YPD 培養基, Sigma Aldrich
海藻糖, Sigma Aldrich
脫脂奶粉
瓊脂
去離子水
液氮
器材:
玻璃培養皿
液氮杜瓦瓶
3
實驗
本應用中描述的工作是在無菌條件下進行的。將 84g 市售面包酵母懸浮溶解在 50mL 無菌 YPD 培養基(Sigma Aldrich)中。在酵母懸浮液中加入 50mL 無菌凍干保護劑培養基(5g 海藻糖(Sigma Aldrich)和 5g 脫脂牛奶溶于去離子水中),然后用微膠囊造粒儀 B-390 進行制粒(表1)。將擠壓后的液滴收集在液氮浴中冷凍,然后轉移到不銹鋼托盤中,保存在 -25°C 的冰箱中進行冷凍干燥。
表1:微膠囊包埋參數
300μm 噴嘴 | 1mm 噴嘴 | |
頻率[Hz] | 680 | 60 |
電壓[V] | 750 | 2500 |
壓力[mbar] | 500 | 500 |
冷凍干燥步驟(初級干燥和次級干燥)使用 LyovaporTM 編程軟件,如表 2 所示。使用 LyovaporTM L-200 Pro 干燥腔體、可加熱的擱板和環境空氣。
表2:初級干燥和次級干燥凍干參數

無酵母菌微球采用與含酵母菌微球相同成分培養基和參數進行制備。
冷凍干燥后,將 1mL 無菌水加入 1mL 微球中,用以復原樣品。對于含有酵母菌的菌珠,對每個重組溶液進行10倍、100 倍和 1000 倍的連續稀釋。將復原后的溶液和稀釋液分別涂于 YPD 瓊脂平板上,如圖 1 所示。瓊脂板在 28℃ 培養 24h,評價細胞活力。

▲ 圖1:瓊脂平板上的酵母活力測試
4
結果與討論
含有酵母的微球可以通過使用微膠囊造粒儀 B-390 進行包埋制備,結果表明:用微膠囊造粒儀 B-390 將酵母滴入液氮中,可使酵母迅速顆粒化;用 300μm 的噴嘴和 1mm 的噴嘴分別制備了 700μm 和 1500μm 左右的微球。僅使用含凍干保護劑介質的溶液也得到了類似的結果。如圖 2 所示,凍干后的微球在形狀和大小上與濕凍微球保持相似。


▲ 圖2:用微膠囊造粒儀 B-390 制得的 300μm 酵母微球,在凍干前(左)后(右)的對比
通過掃描電鏡對其結構進行分析。在圖 3 中,可以觀察到含有酵母的球珠(下兩圖)和僅由凍干保護劑培養基制成的球珠(上兩圖)在形態上的差異。含有酵母菌的微球具有由 5μm 顆粒組成的粗糙結構,可以認為是微生物,而只含有凍干保護劑的微球具有更光滑的結構。




▲ 圖3:含酵母菌的凍干微球(下)和不含酵母菌凍干微球(上)的結構對比
當冷凍干燥時,考慮到膜中脂質物理狀態的變化或由于某些蛋白質結構的變化,生物系統可能受到破壞3,9。為了驗證酵母菌的活力,將酵母菌重新水合,稀釋,并在 28°C 的 YPD 瓊脂板上培養 24 小時。圖 4 證實了文獻報道的內容,即便失去了部分活力,酵母在凍干后仍然可以生長2,4,6,10。

▲ 圖4:在 28℃ 瓊脂板中培養 24 小時后的酵母菌活力
5
結論
含有酵母菌的微粒可以很容易地用微膠囊造粒儀 B-390 進行制備,并使用凍干機 LyovaporTM L-200 進行冷凍干燥處理。B-390 的噴嘴直徑分別為300 μm和1000 μm,制得的微粒直徑分別為 700μm 和 1500μm。冷凍干燥后,珠粒的大小和形狀沒有變化。該顆粒流動性好,容易掌握使用劑量,且與水混合后溶解速度快。凍干后的微生物在貯藏過程中仍能保持良好的活力,并能在復水化后成功生長。
在本應用中,造粒包埋和冷凍干燥的結合顯示出了非常好的實驗結果。它可以在發酵工藝和食品轉化等領域開辟新的可能性,有利于生產制備劑量易控制和重組的培養發酵劑;另外,在益生菌和食品補充劑領域中獲得無塵且可自由流動的粉末,同時保證產品顆粒大小和組成的均勻度。
6
參考文獻

長按上方二維碼聯系我們
或撥打聯系電話:
400 - 880 - 8720
微信公眾號
步琦智慧實驗室
淘寶官方旗艦店
瑞士步琦
最新動態
更多





虛擬號將在 秒后失效
使用微信掃碼撥號